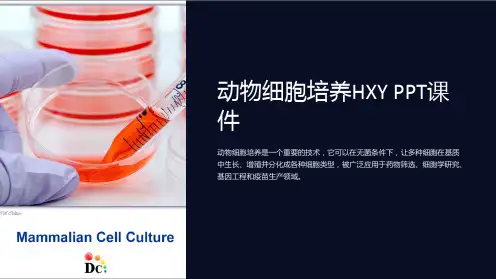

第七章 动物细胞培养
- 格式:ppt
- 大小:1.63 MB
- 文档页数:52

《动物细胞培养技术及其应用》讲义一、动物细胞培养技术的概述动物细胞培养是指在体外模拟体内环境,将动物细胞从机体中取出,在无菌、适当温度和一定营养条件下,使之生存、生长并维持其结构和功能的一种技术。
这项技术的发展有着重要的意义。
它为研究细胞的生理、生化、遗传等方面提供了理想的实验模型,也为生物制品的生产,如疫苗、抗体等,开辟了新的途径。
二、动物细胞培养的基本条件1、无菌环境细胞培养必须在无菌条件下进行,以防止微生物的污染。
这包括对培养器具的严格消毒,操作过程中的无菌操作技术,以及培养环境的清洁和定期消毒。
2、营养条件细胞需要各种营养物质来维持生长和代谢。
常见的营养成分包括葡萄糖、氨基酸、维生素、无机盐等。
此外,还需要添加血清,血清中含有多种生长因子和激素,对细胞的生长和分化起着重要的调节作用。
3、适宜的温度和 pH 值大多数动物细胞适宜的培养温度在 37℃左右,pH 值在 72 74 之间。
保持稳定的温度和 pH 值对于细胞的正常生长至关重要。
4、气体环境细胞培养需要一定的气体环境,通常是 95%的空气和 5%的二氧化碳。
二氧化碳可以调节培养液的 pH 值,维持其稳定性。
三、动物细胞培养的基本方法1、原代培养原代培养是指从机体取出细胞后,在体外首次培养的过程。
原代培养的细胞具有较强的活力和分裂能力,但培养过程相对复杂,需要较高的技术水平。
2、传代培养当原代培养的细胞生长到一定密度时,需要将其分成若干份,重新接种到新的培养容器中继续培养,这个过程称为传代培养。
传代培养可以使细胞不断增殖,以便进行更深入的研究和应用。
3、细胞系和细胞株经过长期传代培养的细胞会形成细胞系。
而从细胞系中筛选出具有特定性质和标记的细胞,则称为细胞株。
细胞系和细胞株的建立为细胞研究和生物制品生产提供了稳定的细胞来源。
四、动物细胞培养的应用领域1、生物制药动物细胞培养在生物制药领域有着广泛的应用。
通过培养动物细胞,可以生产各种生物制品,如疫苗、抗体、激素等。

动物细胞培养
动物细胞培养是一种重要的生物技术手段,广泛应用于医药、生物学研究、食
品工业等领域。
通过细胞培养,可以获取大量同质的细胞群体,为疾病治疗、新药研发提供重要的支持。
动物细胞培养的原理
动物细胞培养是将动物组织或细胞在人工培养基中进行维持、增殖、传代等过程。
培养基通常包括营养物质、生长因子、激素等成分,提供细胞生长所需的营养和环境。
动物细胞培养的步骤
1.细胞来源:从动物体内收集组织样本,获得原代细胞。
2.细胞分离:通过消化酶等手段将组织分离成单个细胞。
3.传代培养:将分离的细胞在培养基中培养,定期传代以增殖细胞数
量。
4.检测与分析:对培养的细胞进行检测、分析,确保其健康状态。
动物细胞培养的应用
1.生物医学研究:细胞培养在癌症、遗传疾病等方面的研究中发挥重
要作用。
2.药物研发:通过细胞培养可以进行药物筛选、毒性测试等工作。
3.食品工业:利用细胞培养技术可以生产细胞培养肉等食品。
动物细胞培养的发展
随着生物技术的不断发展,动物细胞培养技术也在不断创新和提升。
新的培养
基配方、生长因子的发现以及工程技术的应用,使得动物细胞培养在医学和生物学领域有着广阔的应用前景。
动物细胞培养作为一种重要的生物技术手段,将继续在各个领域发挥重要作用,为人类健康和科学研究进步做出贡献。




《动物细胞培养技术及其应用》讲义一、动物细胞培养技术的概述动物细胞培养是指从动物体内取出细胞,在体外模拟体内的生理环境,使其生长、分裂和分化的技术。
这一技术的发展为生物学、医学等领域的研究提供了强大的工具。
细胞培养的基本条件包括合适的培养基、无菌环境、适宜的温度和气体条件等。
培养基通常包含细胞生长所需的营养物质,如氨基酸、维生素、无机盐等,还可能添加血清等成分来提供额外的生长因子。
无菌环境是细胞培养成功的关键,任何微生物的污染都可能导致培养失败。
培养箱能提供恒定的温度和气体环境,一般来说,哺乳动物细胞培养的温度在 37℃左右,同时需要一定比例的氧气和二氧化碳。
二、动物细胞培养的基本方法1、原代培养原代培养是指直接从动物组织或器官中获取细胞进行的首次培养。
首先,需要将组织剪碎并进行消化处理,以分离出单个细胞。
常用的消化酶有胰蛋白酶、胶原酶等。
然后,将细胞悬浮在培养基中,接种到培养容器中进行培养。
2、传代培养当原代培养的细胞生长汇合形成单层时,需要进行传代培养。
这通常通过胰蛋白酶消化使细胞从培养容器表面脱离,然后将细胞按一定比例分装到新的培养容器中继续培养。
3、细胞系和细胞株经过多次传代培养后,有些细胞能够无限增殖,形成细胞系。
而从细胞系中筛选出具有特定性质的细胞,如稳定表达某种蛋白或具有特定基因突变的细胞,就形成了细胞株。
三、动物细胞培养技术的应用1、生物制品生产动物细胞培养技术在生物制品的生产中发挥着重要作用。
例如,通过培养动物细胞可以生产疫苗、抗体、激素等生物制品。
疫苗的生产可以通过培养病毒感染的细胞,然后收集病毒进行灭活或减毒处理。
抗体的生产则可以利用杂交瘤技术,将产生抗体的 B 淋巴细胞与骨髓瘤细胞融合,形成能无限增殖并分泌抗体的杂交瘤细胞,通过细胞培养大量生产抗体。
2、基础医学研究在基础医学研究中,动物细胞培养技术为研究细胞的生理、生化过程提供了便利。
可以通过培养不同类型的细胞来研究细胞的分化、凋亡、信号转导等机制。